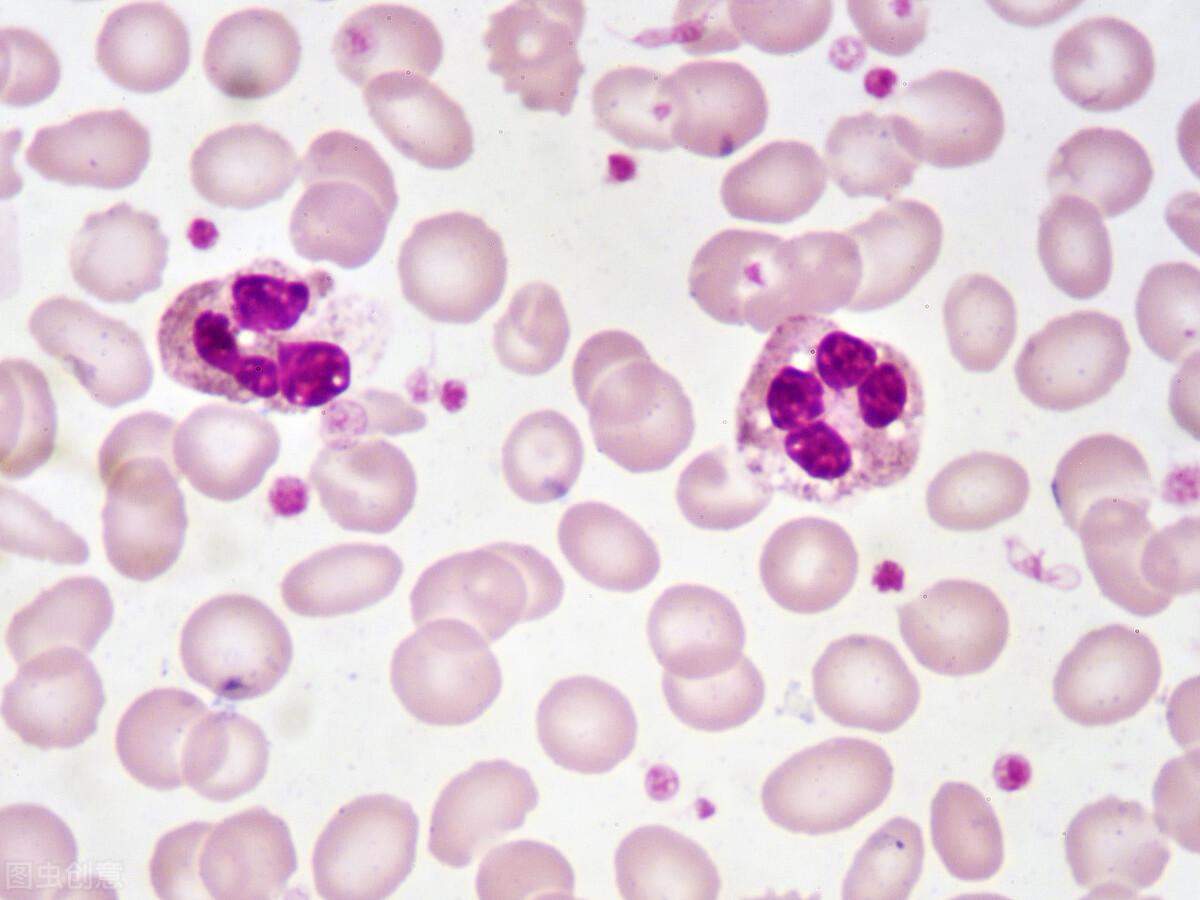

血常规报告单图片 血常规报告单正常值
血常规报告单图片 血常规报告单正常值

血常规报告单
不知道大家发现没有,不管你是什么原因去医院看病,医生一般都会开一个叫血常规的检查,有些地方也叫血细胞分析。
顾名思义,血细胞分析就是主要分析的是血液里的各种血细胞的检查,叫法不同,其实都是一个东西。
可是当你拿着多达二十多个项目的血常规报告,你是否会感到就像天书一样?
别怕,在这里检验菌就带大家认识一下什么叫血常规检查。

血常规检查
血常规是最普通也是最常见的检查,因为很多人在生病的时候,虽然身体没有表现出明显的症状,但是可以通过检查这些细胞的数量和形态变化找到一些疾病的迹象。
所以当医生给你开血常规检查的时候,不要觉得没必要,更不要觉得医院只是想挣你钱。
那么,拿到血常规报告单,该如何去看懂呢?

首先最直观的应该就是报告单上面的↑ ↓了,但是小伙伴们不要看到↑ ↓就紧张,这并不代表你身体就一定有问题。因为检测结果都有个参考区间,这个参考区间适用于大部分人,而并不是所有人,有些生理因素也会影响血液检测结果,如压脉带使用时间、血液采集的部位、保存方式及时间,性别、年龄、种族、居住地的海拔高度、雾霾污染程度,甚至是季节的变化都能对参数产生干扰。
所以如果你身体没有任何症状,且结果只是高了或者低了一点点,都不用太担心
但是检验菌也不是叫小伙伴们完全忽视报告单上面的箭头,如果你的检测结果与正常参考值的差距比较小,但你自己的确有一些不舒服的症状,这就属于【异常值】,可能是疾病早期的提示,这时候就应该要去找专科医生了。

通常情形下,血常规检验报告单是供临床医生辅助诊断用的,虽然血常规价格很便宜
但是当拿到报告单后才发现,原来检查了这么多项目啊!
那是不是所有项目都必须弄懂呢?
检验菌在这里告诉小伙伴,其实血常规报告单只需要看懂这三种数据就够了。
它们就是白细胞、红细胞/血红蛋白和血小板。

白细胞
白细胞
白细胞分为中性粒细胞、嗜酸性粒细胞、嗜碱性粒细胞、单核细胞、淋巴细胞这5类,白细胞是人体抗感染的一道屏障,主要起免疫的作用,如果体内的白细胞数量高于正常值,提示我们体内可能有了炎症。
要具体判断究竟是什么感染引起的炎症,还得注意这3个主要的血象指标:白细胞计数、中性粒细胞比例和淋巴细胞比例。
但是我们也不要看到白细胞数量有变化就吓得不行,因为白细胞数量高低除了疾病的影响,也会受年龄、活动、情绪和女性生理状态等因素影响,波动比较大。
所以要看身体是不是真的有问题,就还需要看下面几个指标。
中性粒细胞
· 中性粒细胞
如果中性粒细胞增高了,那么就可能会出现急性细菌感染、严重的组织损伤及大量血细胞破坏、肿瘤(包括白血病)等。
如果中性粒细胞减少了,就可能是病毒感染、再生障碍性贫血、物理化学损伤、自身免疫性疾病等。
所以不要再一感冒就吃头孢、青霉素这类的抗生素了,谨遵医嘱,找到你的感染是细菌感染还是病毒感染后,再用药

淋巴细胞
· 淋巴细胞
淋巴细胞升高主要见于病毒感染、血液系统肿瘤(淋巴细胞白血病)、急性传染病的恢复期、移植排斥反应、艾滋病毒感染、吸烟者和自身免疫性疾病(如类风湿性关节炎)。
降低则见于免疫缺陷性疾病及射线损伤等

单核细胞
· 单核细胞
婴幼儿及儿童可出现生理性增多,所以不要看到你娃娃单核细胞增高了,就觉得一定有问题,还是要多找医生,听听医生的。
病理性增多主要见于各类感染(感染性心内膜炎、疟疾、黑热病等)以及部分血液病(如单核细胞白血病)。
· 嗜酸性粒细胞
增多主要见于各类过敏性疾病、寄生虫感染以及皮肤病等,减少通常见于伤寒感染初期或者长期激素治疗等。
· 嗜碱性粒细胞
增多见于过敏性疾病及风湿性疾病。
目前还没发现嗜碱性粒细胞减少有明确临床意义。

白血病
注意:下面是重点!
如果发现报告单上白细胞数量突然变得很高,甚至高达几百,并且外周血涂片中还出现了幼稚细胞,这个时候就赶紧去找血液科医生,因为很可能就是白血病!

红细胞
红细胞/血红蛋白
红细胞的生理功能就是通过血红蛋白来实现的。
红细胞和/血红蛋白增多主要见于呕吐、尿崩等可因血浆容量减少而出现相对性增多,慢性缺氧及高原地区居民可出现代偿性红细胞增多,但是肾癌、肝癌以及骨髓增生性疾病则会引起病理性的红细胞增多。
红细胞/血红蛋白减少可能就是因为贫血,这是病理性因素,这就需要尽快出贫血的原因
红细胞/血红蛋白减少还有一种情况就是生理性的减少,主要见于婴幼儿及15岁以下的儿童;老年人造血功能减退;女性在妊娠中、晚期血浆容量明显增多,血液被稀释。这些都是正常情况,不要太担心!

血小板检查
血小板
血小板是人体“修理工”,专门修补破损的血管,并负责凝血,止血。
血小板过多或者过少均会引起凝血功能异常。
血液中的血小板过少时,就要注意是否患上造血系统疾病(再生障碍性贫血),或者脾脏功能亢进。
如果血小板小于20,这个时候就要特别注意了,因为血小板小于20的时候就可能引起内脏的自发性大出血!
血小板的升高常常提示急性感染、急性溶血、骨髓病变,或脾脏于近期被切除
血常规检测虽然很便宜,又很普通,但是通过血常规检测还是可以发现很多疾病的,所以不要忽视血常规检查!
-
- 芈月后来生的孩子怎么样了 芈月的感情
-
2024-02-18 06:30:19
-

- 青瓷主角 青瓷女主角
-
2024-02-18 06:28:05
-

- 成语大全解释近反义词 成语近义词反义词大全带解释
-
2024-02-18 06:25:50
-
- 被截胡的大连,还能重新崛起吗?
-
2024-02-18 06:23:35
-

- 近亲属关系法律范围包括哪些人员 近亲属关系法律范围包括哪些人的关系
-
2024-02-18 06:21:20
-

- 药学专业报考建议怎么写 药学专业报考建议怎么填
-
2024-02-18 06:19:06
-

- 蜗牛吃什么东西(鱼缸红蜗牛吃什么东西)
-
2024-02-17 11:10:35
-

- 苹果浏览器怎么删除历史记录(苹果浏览记录怎么彻底清除)
-
2024-02-17 11:08:20
-

- 侠客风云传武功(侠客风云传武功最高多少级)
-
2024-02-17 11:06:06
-

- 苹果11promax多大屏幕尺寸(苹果11promax的屏幕多大)
-
2024-02-17 11:03:51
-
- 云顶之弈刀妹主c阵容最新(云顶之弈刀妹是)
-
2024-02-17 11:01:37
-
- 移动网络怎么改wifi密码(中国移动网络怎么改wifi密码)
-
2024-02-17 10:59:22
-
- too英语怎么读(too英语怎么读 单词)
-
2024-02-17 10:57:08
-

- 补衣旁的字有哪些字旁的字(补衣字偏旁的字有哪些)
-
2024-02-17 10:54:53
-

- oppo手机返回键怎么调出来(oppo手机返回键怎么调出来A32)
-
2024-02-17 10:52:38
-

- 怎么能通过手机号查到对方的位置(免费教你查一个人的定位)
-
2024-02-17 10:50:24
-

- 电脑存储设置在哪里(电脑存储设置在哪里找)
-
2024-02-17 00:15:36
-

- 怎样彻底删除微信聊天记录不被恢复(怎样彻底删除微信聊天记录不被恢复华为)
-
2024-02-17 00:13:21
-
- ktv女生容易唱的歌(ktv女生容易唱的歌带到气氛)
-
2024-02-17 00:11:07
-
- u盘读不出来(u盘读不出来怎么修复数据)
-
2024-02-17 00:08:52



 同一个id怎么取消共同来电和短信(iphone同一个id怎么取消来电同步)
同一个id怎么取消共同来电和短信(iphone同一个id怎么取消来电同步) 经典黄梅戏家春秋演员
经典黄梅戏家春秋演员